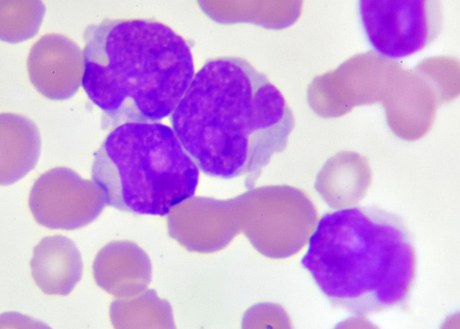
An image of Acute Myeloid Leukemia cells

Two Agents, One Target: The Evolving Landscape of NPM1-Mutated AML
Authors
- Moh'd Mohanad A. Al-Dabet, PhD, AHI(AMT), Acting Chair, Department of Medical Laboratories; Dean's Assistant for Accreditation and Quality Assurance, Faculty of Health Sciences, American University of Madaba (AUM)
- Katia Al-Sawalha, BSc, Medical Laboratory Science Graduate, American University of Madaba (AUM)
- Olivia White, PharmD, BCOP, Hematology Pharmacy Specialist, UT Southwestern Medical Center
Introduction
Acute Myeloid Leukemia (AML) is a hematological malignancy characterized by a clonal, uncontrolled proliferation in the immature myeloid cell lineage in both bone marrow and peripheral blood. It accounts for approximately 80% of adult acute leukemic cases and has significant challenges in clinical treatment due to disease heterogeneity and poor prognosis in relapsed or refractory settings.1 Among different genetic mutations in AML, Nucleophosmin 1 (NPM-1) is one of the most common, with an estimated incidence of 30-35%.2 NPM-1 mutations (NPM-1m) typically involve exon 12 and often have a normal karyotype. In the initial stages, the presence of NPM-1m can be a favorable prognostic indicator, but patients who experience relapse or become refractory to the standard therapies have poor outcomes.3
Menin inhibitors work by disrupting leukemogenesis driven by either lysine methyltransferase 2A rearrangements (KMT2Ar) or NPM-1m. Menin is a scaffold protein that forms a complex with KMT2A and acts to mediate the homeobox (HOX) genes and their DNA-binding cofactor myeloid ecotropic virus insertion site 1 (MEIS1).4-8 Ultimately, through this pathway, the Menin/KMT2A complex contributes to the regulation of normal hematopoiesis. However, in the setting these genetic aberrations, these mediator complexes are less functional, leading to disrupted cellular differentiation and leukemogenesis. The role of NPM1 in this process is not as well elucidated; however, it is thought that once mutated, NPM1 interacts with the KMT2A/Menin complex, leading to this similar enhanced transcription.4 Notably, while inhibition of menin can clinically restore differentiation, it is worth noting that the menin complex only plays a vital role in rearranged/mutated cells versus those that are wild-type. Thus, the use of menin as a therapeutic target is ideal.
Menin inhibitors, such as revumenib (SNDX-5613), ziftomenib (KO-539), bleximenib (JNJ-75276617), and enzomenib (DSP-5336), are therapies currently being studied in this space that target the disruption of this interaction and ultimately lead to the downregulation of oncogenes such as HOX and MEIS1 expressions, promoting leukemic cell apoptosis and cell differentiation.4 Revumenib was the first menin inhibitor FDA approved for relapsed/refractory KMT2A-rearranged AML and ALL in November 2024 and FDA approved for use in relapsed/refractory NPM-1-mutated AML in October of 2025. Additionally, ziftomenib was approved for relapsed/refractory NPM-1-mutated AML as of November 2025, making these agents a rapidly expanding drug class for patients with acute leukemias. The goal of this article is to review these two agents for NPM-1m disease and highlight key considerations when implementing either of these therapies.
Revumenib
Revumenib was FDA approved based on the results of the phase 2 AUGMENT-101 trial, in which patients demonstrated a complete remission (CR) or CR with partial hematological recovery (CRh) rate of 23.1% (95% CI, 13.5-35.2%) in patients with relapsed or refractory NPM-1m AML.9 Revumenib was well tolerated and had a manageable safety profile, with overall low incidence of differentiation syndrome and QTc prolongation (two key adverse events with revumenib), The phase 1/2 AUGMENT-101 trial was an open-label dose-escalation and dose-expansion study evaluating the role of revumenib in both pediatric (≥ 30 days old) and adult patients. AUGMENT-101 included patients with relapsed/refractory acute leukemias who had either KMT2Ar or NPM1m.
Revumenib was administered by mouth every 12 hours in a 28-day continuous cycle. Based on the Phase 1 data, the recommended dose of revumenib was 270 mg every 12 hours or 160mg every 12 hours when administered with a strong CYP3A4 inhibitor. The primary outcome of AUGMENT-101 was CR+CRh and safety analysis. Secondary outcomes included composite complete remission (CRc; CR + CRh + CR with incomplete hematologic recovery + CR with incomplete platelet recovery), overall response rate, time to response, duration of response, event-free survival, and overall survival. The specific NPM1m cohort included 64 patients with a median age of 65, who were evaluated for efficacy, and 84 patients with a median age of 63, who were evaluated for safety.
Of the efficacy cohort, the median (range) of previous lines of therapy were 2 (1-7), with 35.9% of patients receiving ≥3 previous lines. Notably, 40.6% of patients had a co-occurring FLT-3 mutation (either ITD or TKD), and 46.9% of this cohort had previously received a FLT-3 inhibitor. Of the safety cohort, 13.1% of patients were commutated with IDH1 and 11.9% with IDH2. These values were not noted in the efficacy cohort; however, 6% of the mutated patients from each group had received previous IDH-targeted therapy. Additionally, 75% of this group had been previously venetoclax-exposed and 21.9% of patients had received a prior hematopoietic stem cell transplant. The primary endpoint demonstrated a CR+CRh rate of 23.4% (95% CI 13.8-35.7%). Additionally, ORR was achieved in 46.9% of patients. Responses were assessed using the ELN 2017 criteria and with MRD data were not reported. The duration of response was 4.7 months, and median overall survival was approximately 4 months in the efficacy cohort. Notably, for patients who did achieve a CR+CRh, overall survival was prolonged to 23.3 months.
Furthermore, from a safety profile, this study noted an incidence of differentiation syndrome of 19% (Grade ≥3: 13.1%). QTcF prolongation was also noted, with an estimated incidence of 42.9% (Grade ≥3: 22.6%). Other notable high-grade toxicities included febrile neutropenia (33%), thrombocytopenia (14%), anemia (25%), sepsis (15%). Dose modifications occurred in 76.2% of patients and 66.7% of patients required a treatment interruption. Notably, one patient died due to a possible treatment-related event (cardiac arrest).
Ziftomenib (KO-539)
Similar to revumenib, ziftomenib is another menin inhibitor that has demonstrated clinical activity in patients with relapsed or refractory NPM1m AML. The primary trial driving ziftomenib’s approval is the KOMET-001 study.10 KOMET-001 was a multi-center, open-label, phase 1/2 clinical trial assessing the role of ziftomenib in adults with relapsed or refractory AML. Eligible patients were adults with relapsed/refractory NPM1m AML. The primary endpoint of KOMET-001 was CR+CRh. Secondary endpoints included duration of response, cCR, overall response rate, time to first response, MRD negativity, overall survival, transfusion independence, and safety. Based on Phase 1 data, patients were administered ziftomenib 600mg by mouth daily until intolerance or disease progression.
KOMET-001 included 92 patients with a median age of 69 years. Patients had received a median (range) of 2 (1-7) prior lines of therapy, with 59% receiving previous venetoclax, 24% receiving previous transplant, and 1 patient receiving previous menin inhibitor therapy. Additionally, 55% of these patients were co-mutated with FLT-3, 13% with IDH-1, and 20% with IDH-2. Of these patients, the CR/CRh rate was 23% (95% CI: 15-33) with a median time to CR/CRh of 2.8 months (95% CI: 1-15). Of those who achieved a CR/CRh, 61% were MRD negative at the time of evaluation (confirmed both locally and centrally). Overall response rate was 33%, with a median duration of response of 4.6 months. Median overall survival was 6.6 months.
From a safety perspective, differentiation syndrome was also noted in ziftomenib with 25% experiencing any grade adverse event, and 15% experiencing Grade 3 and no patients having grades 4-5 events. QTcF prolongation was noted in 13% of patients in the entire cohort, with 9% experiencing grade 3-4 events. However, the authors noted that investigator-assessed QTcF prolongation related to ziftomenib was observed in only three patients, all of whom had low grade toxicities. Notably for these three patients, they were all on concomitant medications that additionally contributed to QTcF prolongation. Therefore, based on these findings, the authors concluded ziftomenib lacks a clinically significant risk of QTcF prolongation. Overall, in both the phase I/II cohorts, 4% of patients required doses reduced due to adverse events, 54% needed a dose interruption, and 21% of patients had therapy discontinued due to a treatment-emergent AE while on study.10
Which Agent to Choose?
Together, the clinical evidence supports that both revumenib and ziftomenib demonstrate meaningful activity in patients with NPM1m AML. While cross-trial comparison of efficacy outcomes is futile given the heterogeneity between study populations, the safety profile of both agents as demonstrated in these studies can potentially help when determine which agent is ideal for a specific patient. Table 1 lists key efficacy outcomes of the two Phase I/II trials, while Table 2 compares safety outcomes.
In addition to safety and efficacy outcomes influencing the decision between menin inhibitors, other dissimilarities between the two agents include route of administration and drug interaction profiles. Revumenib is a twice daily medication and needs to be administered on an empty stomach or with a low-fat meal, whereas ziftomenib is once daily on an empty stomach. Additionally, there are data supporting the administration of revumenib in solution if patients have difficulty swallowing that at present does not exist for ziftomenib. Furthermore, revumenib is a CYP3A4 substrate, thus requiring dose adjustments for patients on CYP3A4 inhibitors (as listed in the prescribing information). In comparison, ziftomenib is not a CYP3A4 substrate, but absorption is impacted by gastric acid sequestering agents (e.g. PPIs/H2RAs), and this would need to be considered at time of initiation. Depending on patient’s comorbidities and additional medical needs, these considerations alone could impact the treatment decision between these agents.


Conclusion and Future Directions
In summary, both revumenib and ziftomenib are novel, selective menin inhibitors with a clinical role in NPM1m AML. While currently monotherapy based on single-arm, phase 1/2 trials are the primary clinical trials supporting these agents at-present, future studies can determine the true role for menin inhibition and whether an oral combination regimen would be preferred. One study in particular, the Beat AML Master Trial, published single-arm data earlier in 2025 demonstrating a potential role for revumenib in the front-line setting in combination with azacitidine and venetoclax; however, given the single-arm nature of this trial, this regimen has not been adopted as standard of care and to date is not a recommended first-line approach in clinical guidelines. Other studies similar to this evaluating menin inhibitors in combination are ongoing (e.g. NCT06229912, NCT04067336, NCT05360160, NCT06284486, NCT06746519, NCT07007312, NCT05761171). Additionally, early phase trials assessing other new menin inhibitors, indicating that this mechanism of action will continue to expand within the leukemia treatment paradigm.
While both AUGMENT-101 and KOMET-001 helped to establish menin inhibitors in NPM1m AML, both studies enrolled heavily pretreated patients and biologically heterogeneous patient populations. Furthermore, given KOMET-001 was strained by immature follow-up (median of 4.1 months) and a high degree of censoring due to the effect of ongoing response, an accurate estimation of true efficacy outcomes have yet to be determined. In contrast, AUGMENT-101 did strengthen the validity of its efficacy analyses by requiring a minimum six months of follow-up, but in contrast omitted MRD assessments, potentially restricting evidence on depth of CR/CRh.
For both agents, differentiation syndrome poses a risk; however, QTcF prolongation seems to be improved with ziftomenib, making this a potentially favorable option for patients with previous arrhythmias or scenarios in which QTc prolongation could be of concern. Additionally, ziftomenib is only taken once daily and is not metabolized by CYP3A4, unlike revumenib, and so this agent is potentially favorable from both an adherence perspective and drug-interaction perspective. It is evident that the landscape for NPM1m AML is changing and menin inhibitors are expanding these patients’ therapeutic arsenals. Future studies will hope to elucidate real world outcomes with these agents and when targeted therapy should be incorporated in the current leukemia algorithm.
References
1.Sharma N, Liesveld JL. NPM 1 Mutations in AML-The Landscape in 2023. Cancers (Basel). 2023;15(4):1177. Published 2023 Feb 12. doi:10.3390/cancers15041177
2.Ranieri R, Pianigiani G, Sciabolacci S, et al. Current status and future perspectives in targeted therapy of NPM1-mutated AML. Leukemia. 2022;36(10):2351-2367. doi:10.1038/s41375-022-01666-2
3.Falini B. NPM1-mutated acute myeloid leukemia: New pathogenetic and therapeutic insights and open questions. Am J Hematol. 2023;98(9):1452-1464. doi:10.1002/ajh.26989
4.Issa GC, Aldoss I, DiPersio J, Cuglievan B, Stone R, Arellano M, Thirman MJ, Patel MR, Dickens DS, Shenoy S, Shukla N, Kantarjian H, Armstrong SA, Perner F, Perry JA, Rosen G, Bagley RG, Meyers ML, Ordentlich P, Gu Y, Kumar V, Smith S, McGeehan GM, Stein EM. The menin inhibitor revumenib in KMT2A-rearranged or NPM1-mutant leukaemia. Nature. 2023 Mar;615(7954):920-924. doi: 10.1038/s41586-023-05812-3. Epub 2023 Mar 15. PMID: 36922593; PMCID: PMC10060155.
5.Shimony S, Stahl M, Stone RM. Acute Myeloid Leukemia: 2025 Update on Diagnosis, Risk-Stratification, and Management. Am J Hematol. 2025 May;100(5):860-891. doi: 10.1002/ajh.27625. Epub 2025 Feb 12. PMID: 39936576; PMCID: PMC11966364.
6.Candoni A, Coppola G. A 2024 Update on Menin Inhibitors. A New Class of Target Agents against KMT2A-Rearranged and NPM1-Mutated Acute Myeloid Leukemia. Hematol Rep. 2024 Apr 18;16(2):244-254. doi: 10.3390/hematolrep16020024. PMID: 38651453; PMCID: PMC11036224.
7.Niscola P, Gianfelici V, Giovannini M, Piccioni D, Mazzone C, Fabritiis P. Menin Inhibitors: New Targeted Therapies for Specific Genetic Subtypes of Difficult-to-Treat Acute Leukemias. Cancers (Basel). 2025 Jan 4;17(1):142. doi: 10.3390/cancers17010142. PMID: 39796769; PMCID: PMC11720583.
8.Nadiminti KVG, Sahasrabudhe KD, Liu H. Menin inhibitors for the treatment of acute myeloid leukemia: challenges and opportunities ahead. J Hematol Oncol. 2024 Nov 18;17(1):113. doi: 10.1186/s13045-024-01632-8. PMID: 39558390; PMCID: PMC11575055.
9.Arellano ML, Thirman MJ, DiPersio JF, et al. Menin inhibition with revumenib for NPM1-mutated relapsed or refractory acute myeloid leukemia: the AUGMENT-101 study. Blood. 2025;146(9):1065-1077. doi:10.1182/blood.2025028357
10.Eunice S. Wang, et al. Ziftomenib in Relapsed or Refractory NPM1-Mutated AML. J Clin Oncol 43, 3381-3390(2025). doi:10.1200/JCO-25-01694
11.Joshua F. Zeidner et al. Azacitidine, Venetoclax, and Revumenib for Newly Diagnosed NPM1-Mutated or KMT2A-Rearranged AML. J Clin Oncol 43, 2606-2615(2025). DOI:10.1200/JCO-25-00914